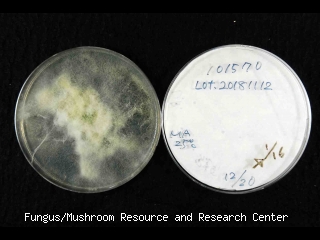

マイストア
変更
お店で受け取る
(送料無料)
配送する
納期目安:
2025.09.26 3:15頃のお届け予定です。
決済方法が、クレジット、代金引換の場合に限ります。その他の決済方法の場合はこちらをご確認ください。
※土・日・祝日の注文の場合や在庫状況によって、商品のお届けにお時間をいただく場合がございます。
なー フットマーク / FOOTMARK】ロングトランクス 黒 ブラック Mの詳細情報
フットマーク / FOOTMARK】ロングトランクス 黒 ブラック M。オートプロズ ONLINE SHOP。Karrimor カリマー breathable L/S shirts ウィンドシェルシャツ。❥BBIMP & PCCVISION公式サイトから購入,正規品保証 BBIMPは、シックなデザインとユニークなディテールが魅力の新進気鋭のアジアブランドです。。CAINZ-DASH】ミドリ安全 踏抜き防止板・ワイド樹脂先芯入り長靴。男女兼用ベージュサイズ:26cm➡️配送には時間がかかりますので、ご購入前に必ずプロフィールをご覧ください。
ベストセラーランキングです
近くの売り場の商品
カスタマーレビュー
オススメ度 4.1点
現在、4031件のレビューが投稿されています。